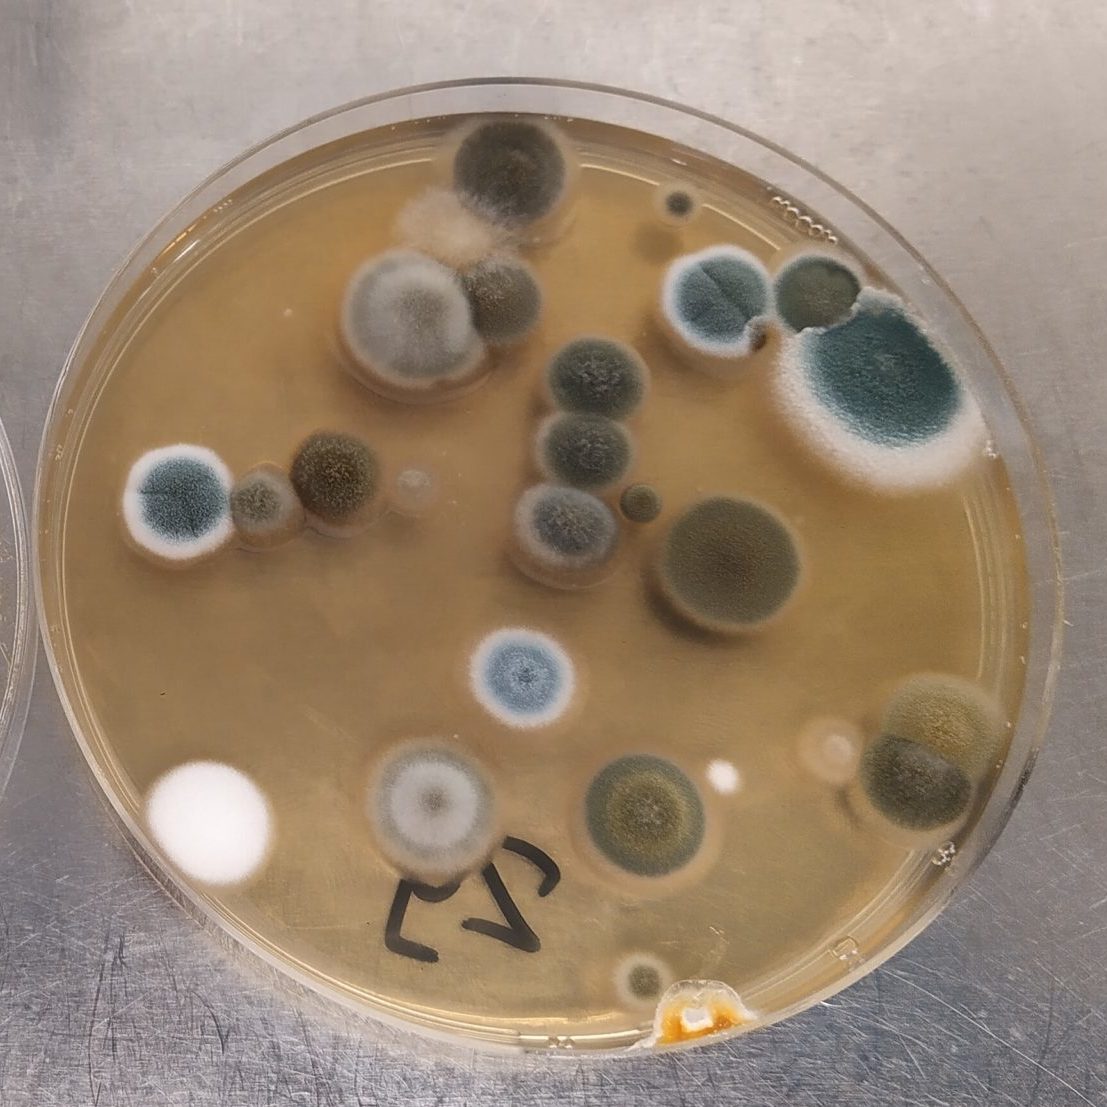

Moisissures
Expertises et Diagnostics
Problèmes récurrents de moisissures ?
Tout environnement humide favorise l’apparition des moisissures. Les pièces les plus souvent touchées sont généralement les salles de bain et les pièces de vie. Les moisissures peuvent se développer rapidement et silencieusement, tout en se propageant derrière les revêtements des murs (peintures, papier-peint) et dans les matériaux de construction (plâtre, isolation, bois, etc…).
Malgré leurs aspects inoffensifs, une contamination représente des risques sanitaires pour les occupants.
Détermination des causes et origines des moisissures
Pour pouvoir combattre efficacement les moisissures, il convient au préalable de déterminer les comment et pourquoi de leur présence.
Une visite des locaux sur site, l’évaluation de l’étendu des proliférations de moisissures, l’observation des habitudes de vie des occupants et autres précieuses informations récoltées auprès de ces derniers, permet d’avoir une vision globale de la situation.
Des outils tels que des études par thermographie infrarouge, des mesures d’humidité dans les matériaux et l’étude du climat ambiant, permettent d’aider à poser le diagnostic.
Une fois leurs causes et origines établies, des solutions correctrices et des solutions de préventions sont proposées afin d’éviter tout nouveaux risques de prolifération de moisissures.

Évaluation des risques sanitaires
De nombreuses études ont démontré que la présence d’humidité et de moisissures dans les pièces habitables a une conséquence néfaste sur la santé des occupants. Les risques augmentent avec l’ampleur de la contamination.
L’exposition aux moisissures est associée à des symptômes respiratoires, à de l’asthme et à des allergies.
L’augmentation du nombre des personnes développant des allergies (et/ou a l’asthme) fait croitre indirectement le nombre des personnes sensibles aux effets des moisissures.
Une partie de l’investigation du risque liée à la présence des moisissures dans les habitations consiste en l’identification de la présence d’humidité.
Nous utilisons tous les outils modernes de détection, passant par les inspections par camera thermographiques et par la mesure de l’humidité dans les matériaux de construction.
Nous vous proposons un support complet, de la phase de l’évaluation de l’étendue des contaminations et leur élimination ainsi que des propositions d’améliorations et recommandations.

Le saviez-vous ?
En Suisse, environ un quart des ménages est concernés par des problèmes de moisissures et d’humidité.
Prélèvements et analyses
Une analyse microbiologique de l’air ambiant permet de quantifier et d’identifier plusieurs micro-organismes biologiques comme les bactéries, moisissures et levures.
Un volume d’air prédéfini est aspiré et plaqué, grâce à un appareil (impacteur d’air), sur des géloses de prélèvements qui sont ensuite retournées en laboratoire pour une mise en culture et une analyse microbiologique.
Des prélèvements de surfaces permettent également de quantifier et d’identifier le type de moisissures.
Rapport d’expertise
Un rapport d’expertise est élaboré après un diagnostic ou une expertise. Le rassemblement des différentes informations reçues par les occupants et les diverses mesures effectuées nous permettent d’établir un rapport clair et précis sur l’étendue de la prolifération, les causes de la prolifération des moisissures ou les risques pour la santé.
Des recommandations à court, moyen ou long terme sont réfléchies et notifiées au besoin. Un suivi peut être effectué dans un deuxième temps afin de s’assurer de la bonne application des recommandations (Diminution de ponts de froid, assèchement des matériaux, mesures de l’humidité sur le long terme).

Moisissures
Le terme moisissure désigne de manière très générale plusieurs familles de microorganismes filamenteux regroupant plus particulièrement des champignons microscopiques. Les moisissures sont naturellement présentes dans notre environnement et nos habitations.
Si ces microorganismes sont utiles dans la fermentation de certains de nos aliments (yaourts, fromages, pains, bière, etc.), certaines moisissures sont connues pour être allergisantes et peuvent émettre des substances toxiques. En cas de prolifération excessive, même les moisissures usuelles et normalement bénignes sont susceptibles de poser un problème pour la santé des occupants des locaux.
Les moisissures prolifèrent en milieu humide. La recherche des sources d’humidité (fuites d’eau, remontées capillaires, ponts froids, etc.) est une étape nécessaire à la réalisation d’un assainissement complet et durable. En cas d’inondations et de dégâts des eaux, le risque de prolifération de moisissures est particulièrement élevé.
En fonction de leur cycle de vie et de leur environnement, les moisissures sont susceptibles d’émettre dans l’air des spores et divers composés organiques volatils (m-COV) responsables des odeurs de « moisi ». Cette odeur de « moisi », sans moisissures apparentes, est un signal à ne pas négliger. Les moisissures sont susceptibles de proliférer dans des endroits difficilement accessibles.

Micrographie électronique d’Aspergillus fumigatus.
Image reproduite avec l’aimable autorisation de Visões da Alma. Avec l’aimable autorisation du professeur Assoc Frank Gaillard, Radiopaedia.org. De l’affaire rID: 8690
Au secours, j’ai des moisissures chez moi !
Cas simple
Les traces de moisissures superficielles ne dépassent pas 100 cm² (10 x 10 cm) à un seul endroit et dans une seule pièce de l’habitat ?
Pas de soucis, après notre expertise, nous pouvons vous conseilleur afin d’éliminer vous-même ces traces de moisissure à l’aide d’un produit fongicide (eau de javel par exemple).

Cas moyen
Les traces de moisissures s’étendent jusqu’à 0,5 m² (70 x 70 cm) à un seul endroit et dans une seule pièce, ou les moisissures sont denses jusqu’à 100 cm² ?
Ce cas est plus complexe. Si vous êtes une personne à risque (fibrose cystique, allergique, asthmatique, immunodéprimé), il est fortement déconseillé d’éliminer par vous-même ces moisissures.
Un appel à des spécialistes est fortement recommandé. Une recherche de la cause de l’excès d’humidité est essentielle pour garantir un assainissement durable.

Cas complexe
Les moisissures de surface s’étendent sur une surface de plus de 0,5 m², ou s’étendent en profondeur. La prolifération atteint plusieurs endroits dans la pièce ou plusieurs pièces dans l’habitat.
La situation est potentiellement dangereuse pour les occupants. Les pièces présentant une importante contamination par les moisissures doivent être isolées et à titre préventif non utilisées.
Une expertise par un spécialiste en physique du bâtiment et un assainissement dans les règles de l’art par une entreprise spécialisée est très fortement recommandée.

Selon la brochure « Attention aux moisissures » édictée par l’Office Fédérale de la santé publique que vous retrouverez en cliquant ici.
